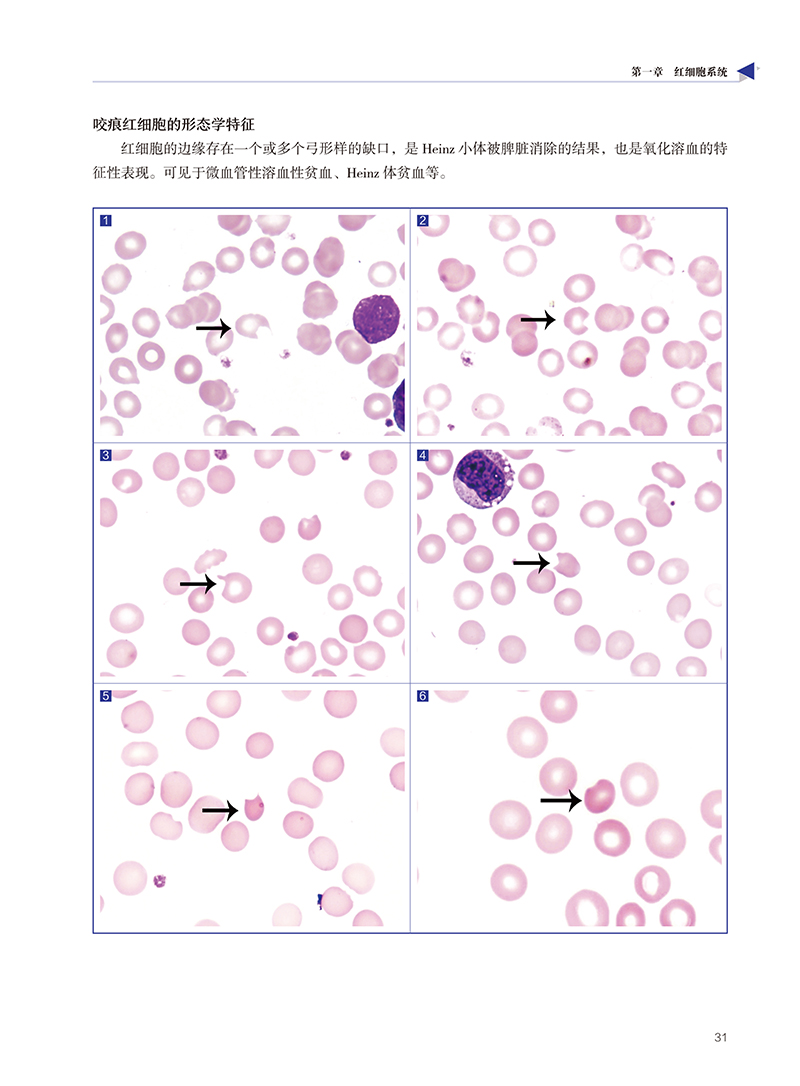

商品详情
本图谱面向的重点读者群为新上岗的检验师,以及离开临床检验岗位时间较长的检验师,能帮助其快速提升或恢复外周血异常细胞识别能力,减少漏诊或误诊的发生,提升基层医院检验结果的信任度,切实有效提高基层医院防病治病和健康管理的能力。
赵岩,中国医科大学检验科主治医师,发表过多篇检验类学术论文,在临床检验方面积累了丰富的工作经验。尤其擅长血细胞检验的诊断。
为了更好地提高检验室工作人员识别细胞形态的水平,减少日常工作对异常血细胞常规检测的漏诊、误诊,特编辑本图谱。本图谱较其他的血细胞形态学图谱更侧重于外周血细胞形态,且部分异常形态的细胞取自患者外周血涂片。这本图谱主要分为两个篇章。第一篇为血细胞形态学,包含红细胞系统、粒细胞系统、巨核细胞系统、单核细胞系统、淋巴细胞系统、浆细胞系统等九张内容。该部分详尽介绍了各细胞系统的正常形态学特征和大部分异常形态学特征、外周血可能出现的异常细胞和常见病原体等内容。第二篇为外周血DI-60图片集,分为外周血白细胞、外周血红细胞和外周血血小板图片集这三章。该部分主要是对外周血DI-60图片库的收集整理,为外周血常见的正常和异常的血细胞形态。

- 辽宁科学技术出版社自营店
- 科学·技术·生活·童趣
- 扫描二维码,访问我们的微信店铺